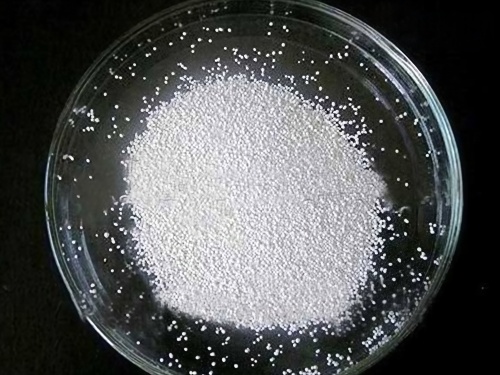

磺酰脲类除草剂主要是在上世纪80年代发展起来的一类高效除草剂。这类除草剂具有除草活性高、用量低(2~100g/hm2)的特点,目前已商品化品种有30余种。这类除草剂仅2003年一年创造的年销售额达16.3亿美元,占全球除草剂总销售额的12.2%。
在磺酰脲类除草剂的生产中,2-氨基-4,6-二甲氧基嘧啶是其合成的重要中间体,以其为合成的除草剂原料品种甚多,如烟嘧磺隆、苄嘧磺隆、吡嘧磺隆、嘧啶磺隆、矾嘧磺隆、乙氧嘧磺隆、酞嘧磺隆等。
目前关于ADMP的主流制备方法中,以丙二腈为原料的工艺路线一直被重点关注,在芳香化环合反应步骤中采取无溶剂法,所得粗品经高真空蒸馏,再引入有机溶剂为分散剂进行结晶、造粒,从而获得纯品。该方案成本低,操作简单,对已有工艺的工业化实行起到了切实的推进作用,其中分散剂的选择集中于甲苯、二甲苯等常见有机溶剂,但在工业化实施过程中发现依然存在以下弊端:
(1) 增加生产成本。分散剂对产品有一定溶解度,造成产品损失,同时还需回收套用,产生操作成本。
(2) 存在安全隐患。甲苯类有机溶剂在过滤及烘干过程中,由于自身易燃、闪点较低等因素,有诱发失火等隐忧;
(3) 存在一定环保压问题。由于甲苯类分散剂用量较大,在使用过程中(如产品过滤、分散剂回收及母液处理等),会导致它的挥发及渗漏,增加挥发性有机化合物(VOC,volatile organic compounds)对工厂环境的污染,影响作业工人的身体健康。
无锡双瑞研制的筒锥式反应过滤干燥多功能机,一机多用,可在一台机内完成反应、萃取结晶、过滤、反复多次过滤洗涤、干燥等多种操作,并直接得到成品,其独特优越性满足操作简便、零 污染、高收率、高品质的获得2-氨基-4,6-二甲氧基嘧啶的纯品的后处理工艺要求。

(1) 搅拌反应:本机为筒锥式结构,可在本机内对物料进行加热或冷却的恒温定时反应;蒸馏冷却后得到的产品中加入纯水和稳定剂,加热至75℃~95℃融化,然后边搅拌边缓慢降温至30℃~50℃
(2) 压滤或真空过滤:当反应完后,通过压滤或真空吸滤、过滤滤液,在过滤阶段,由于螺带与过滤介质的良好贴合刮壁作用,可使物料在薄层滤饼条件下进行过滤,过滤效率高;
(3) 可多次洗涤过滤:过滤滤干后物料,可以加入洗涤液,在机内和物料进行多次自动反应混合再洗涤,洗涤过滤达到洗涤要求后再滤干。
(4) 真空干燥出料:物料过滤滤干后,在干燥间段筒体夹套及空心轴和螺带同时对物料进行加热,并在顶部抽真空对物料进行真空低温密闭干燥,干燥后自动密闭出料。滤饼经烘干后得2-氨基-4,6-二甲氧基嘧啶的白色晶粒状纯品。

磺酰脲类除草剂中间体精制专用反应过滤洗涤干燥多功能设备通过改进设备结构和优化工艺流程,提高了ADMP的制备效果,其占地面积少,造价便宜,便于生产加工,劳动强度降低、物料损耗大大减小。而且对于这种有毒或者易燃易爆等对密封要求特别高的操作,尤其适合,对工人身体、周边环境几乎无影响。

